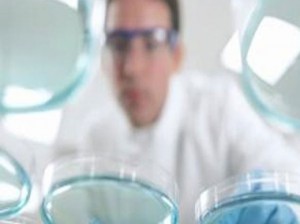

Las 7 enfermedades raras en el mundo
Hay problemas de salud que son tan comunes que han pasado a formar parte de nuestro léxico cotidiano, como es el caso de la diabetes, la obesidad o la migraña. Sin embargo, hay otras patologías que permanecen en la sombra porque son muy poco comunes. A continuación, encontrarás algunas de las enfermedades más raras del mundo:
Hay problemas de salud que son tan comunes que han pasado a formar parte de nuestro léxico cotidiano, como es el caso de la diabetes, la obesidad o la migraña. Sin embargo, hay otras patologías que permanecen en la sombra porque son muy poco comunes. A continuación, encontrarás algunas de las enfermedades más raras del mundo:
1. Síndrome de Cotard. Es una patología psiquiátrica en la cual la persona cree que padece una enfermedad grave. Cuando el trastorno avanza, el paciente cree que sus órganos están descomponiéndose e incluso puede pensar que ya ha muerto.
2. Síndrome de la mano ajena. Se trata de un desorden de origen neurológico en el cual la persona pierde el control de la mano. Esta cobra vida, como si fuese un ente separado de su cuerpo, y puede hacer todo tipo de cosas, incluso contra la voluntad de la persona.
3. Síndrome de Capgras. Se trata de un trastorno psiquiátrico en el cual la persona afectada cree que quienes le rodean (amigos y familiares) son impostores. Es decir, creen que han sido reemplazados por otras personas que quieren hacerle daño.
4. Síndrome de Alicia en el País de las Maravillas. También conocida como micropsia, estas personas perciben los objetos mucho más pequeños de lo que son en realidad. Es un problema que puede aquejar a quienes padecen de migraña y que suele pasar cuando esta remite.
5. Síndrome del acento extranjero. Como lo indica su nombre, esta enfermedad se caracteriza porque un buen día la persona pierde su acento nativo y comienza a hablar su lengua materna como si fuese un extranjero. Normalmente es un efecto secundario a un daño cerebral grave y en las últimas cuatro décadas solo se han reportado unos 60 casos.
6. Progeria de Hutchinson-Gilford. Esta enfermedad afecta a 1 de cada 8 millones de personas y su peculiaridad radica en que los niños envejecen de manera prematura, con tan solo uno o dos años de vida comienzan a sufrir alopecia, piel fina, rigidez articular y todos los problemas propios de la tercera edad.
7. Síndrome del hombre lobo. En el ámbito médico se le conoce como hipertricosis y se refiera a una mutación genética que provoca un crecimiento exagerado del pelo, que llega a cubrir todo el cuerpo, excepto las palmas de las manos y los pies.